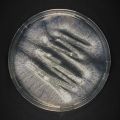
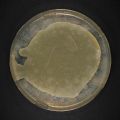
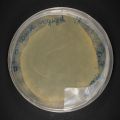

This special page shows the last uploaded files.
- 2022-11-28-Kimchi-Biofilm-Kahm-Yeast-BioArtForum-Katja-Buehler-DSCF7715.jpg Martin.melcher
14:34, 11 December 2022
4,088 × 4,088; 12.52 MB
- 2022-11-28-Kimchi-Biofilm-Kahm-Yeast-BioArtForum-Katja-Buehler-DSCF7703.jpg Martin.melcher
14:34, 11 December 2022
4,160 × 4,160; 9.23 MB
- 2022-11-28-Hibiskus-Kombucha-Danz-Melcher-BioArtForum-Katja-Buehler-DSCF7718.jpg Martin.melcher
14:34, 11 December 2022
4,064 × 4,064; 13.26 MB
- 2022-11-28-Hibiskus-Kombucha-Danz-Melcher-BioArtForum-Katja-Buehler-DSCF7700.jpg Martin.melcher
14:34, 11 December 2022
4,045 × 4,045; 8.44 MB
- 2022-11-28-Bio-Waste-Water-Danz-Melcher-BioArtForum-Katja-Buehler-DSCF7720.jpg Martin.melcher
14:33, 11 December 2022
4,108 × 4,108; 11.72 MB
- 2022-11-28-Bio-Waste-Water-Danz-Melcher-BioArtForum-Katja-Buehler-DSCF7698.jpg Martin.melcher
14:33, 11 December 2022
4,080 × 4,080; 8.66 MB
- Mold, cast - active matter, screen, landscape.jpeg Stefan Ralevic
12:03, 5 December 2022
4,032 × 3,024; 3.42 MB
- Form inhabited by subject - total dasein.jpeg Stefan Ralevic
12:03, 5 December 2022
4,032 × 3,024; 3.41 MB
- Consolidation - postproduction, affect.jpeg Stefan Ralevic
12:02, 5 December 2022
4,032 × 3,024; 2.89 MB